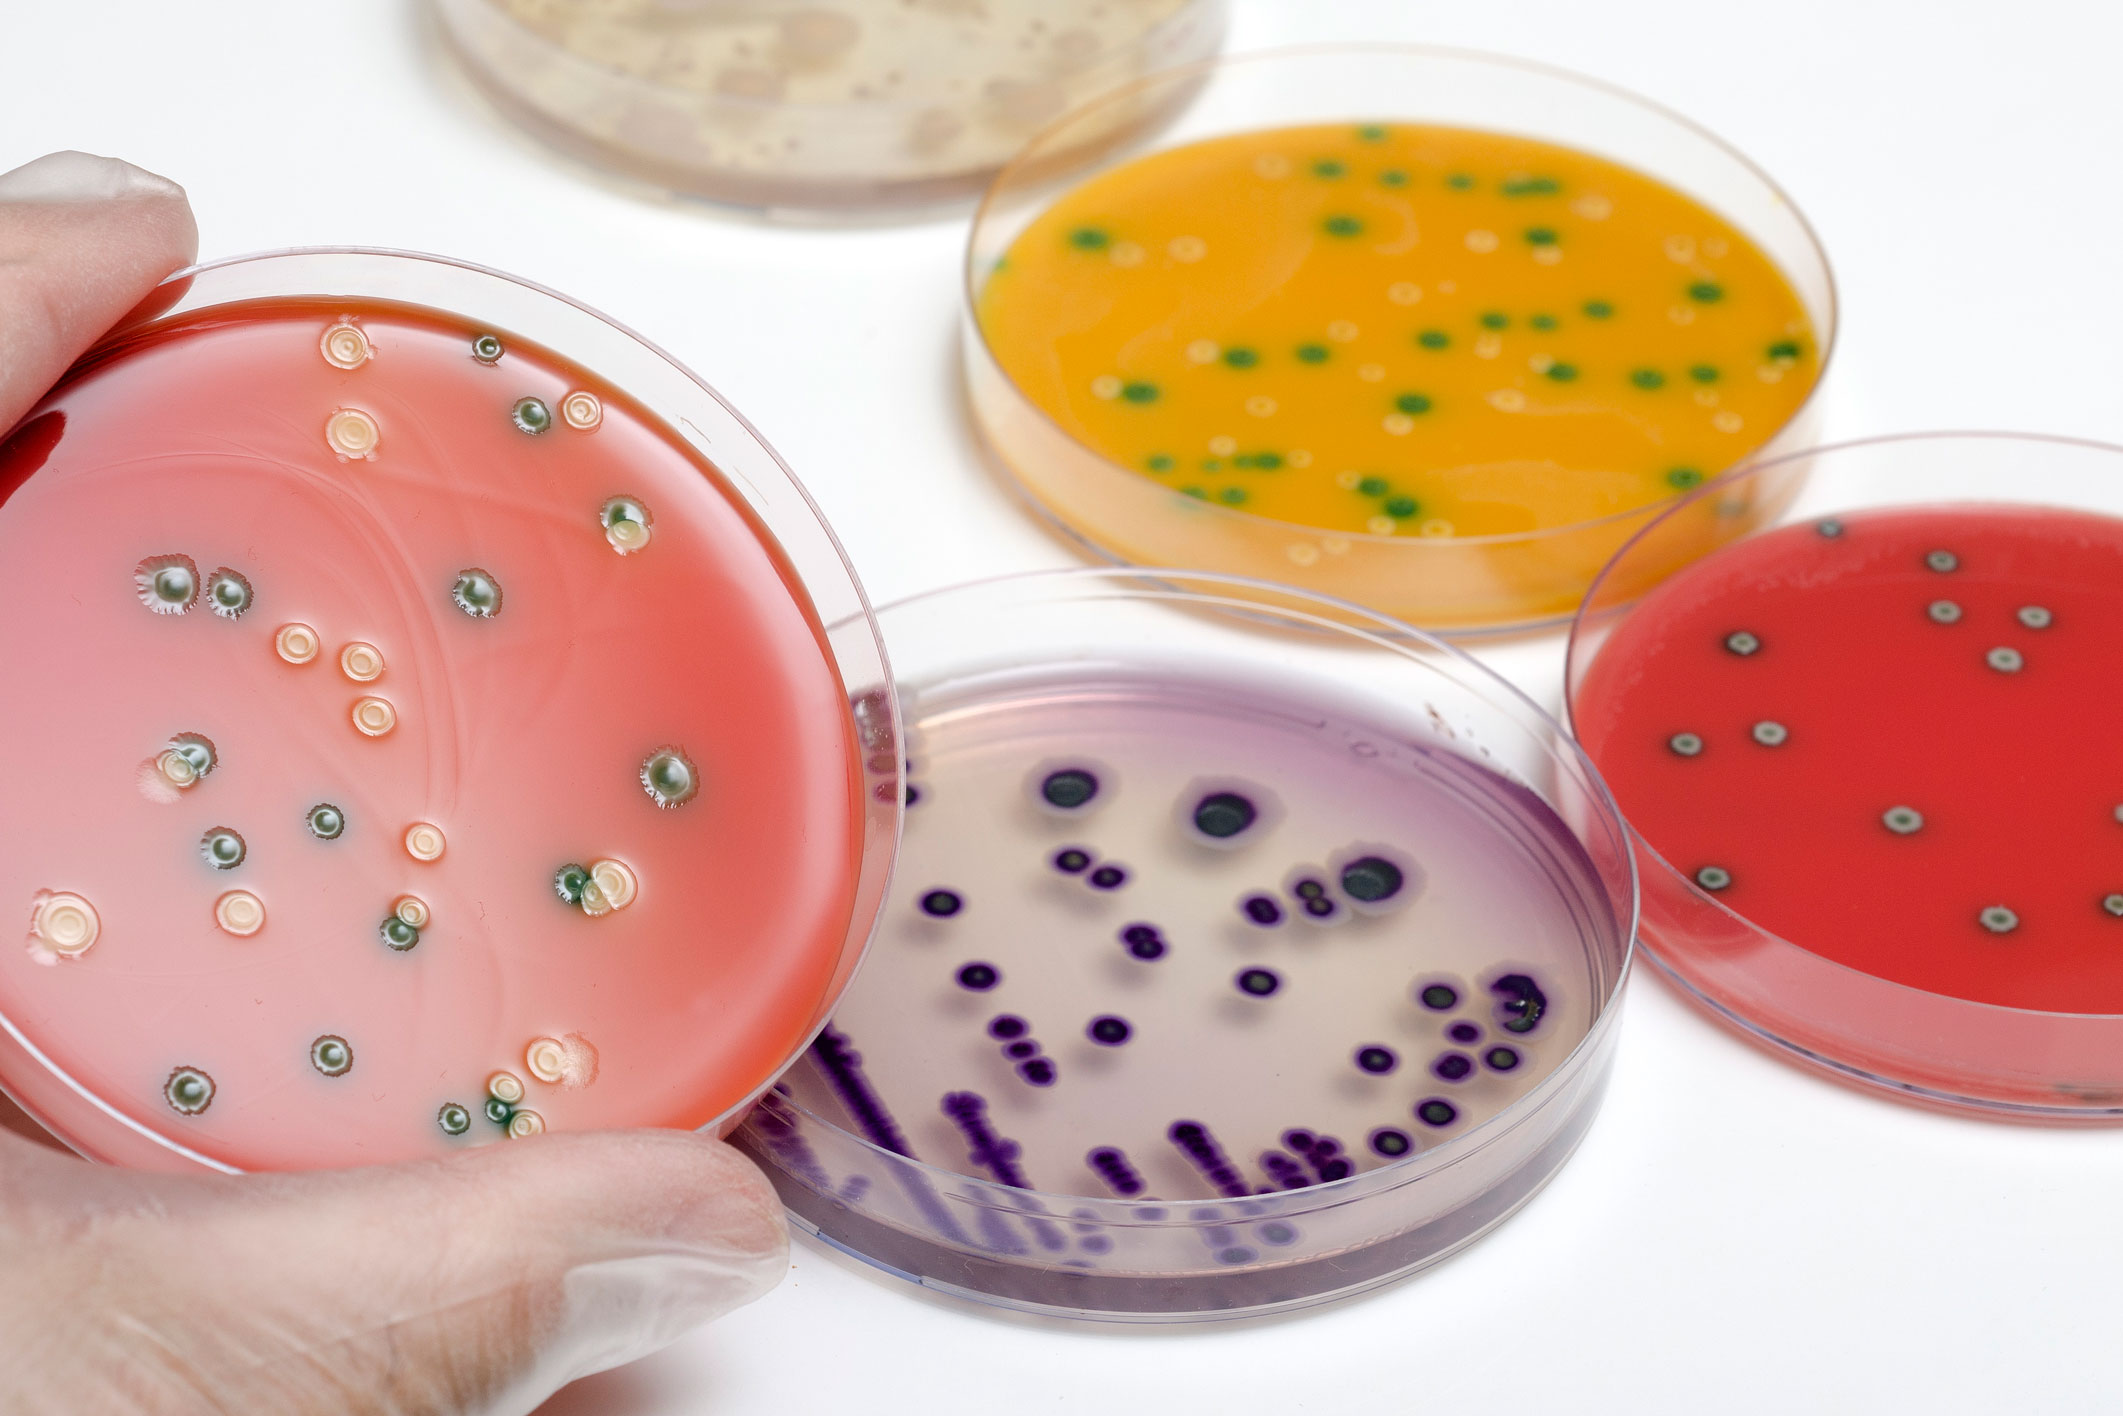

Особенности использования питательных сред МПБ в микробиологии








































































































.jpg)

Раздел: Другие животные